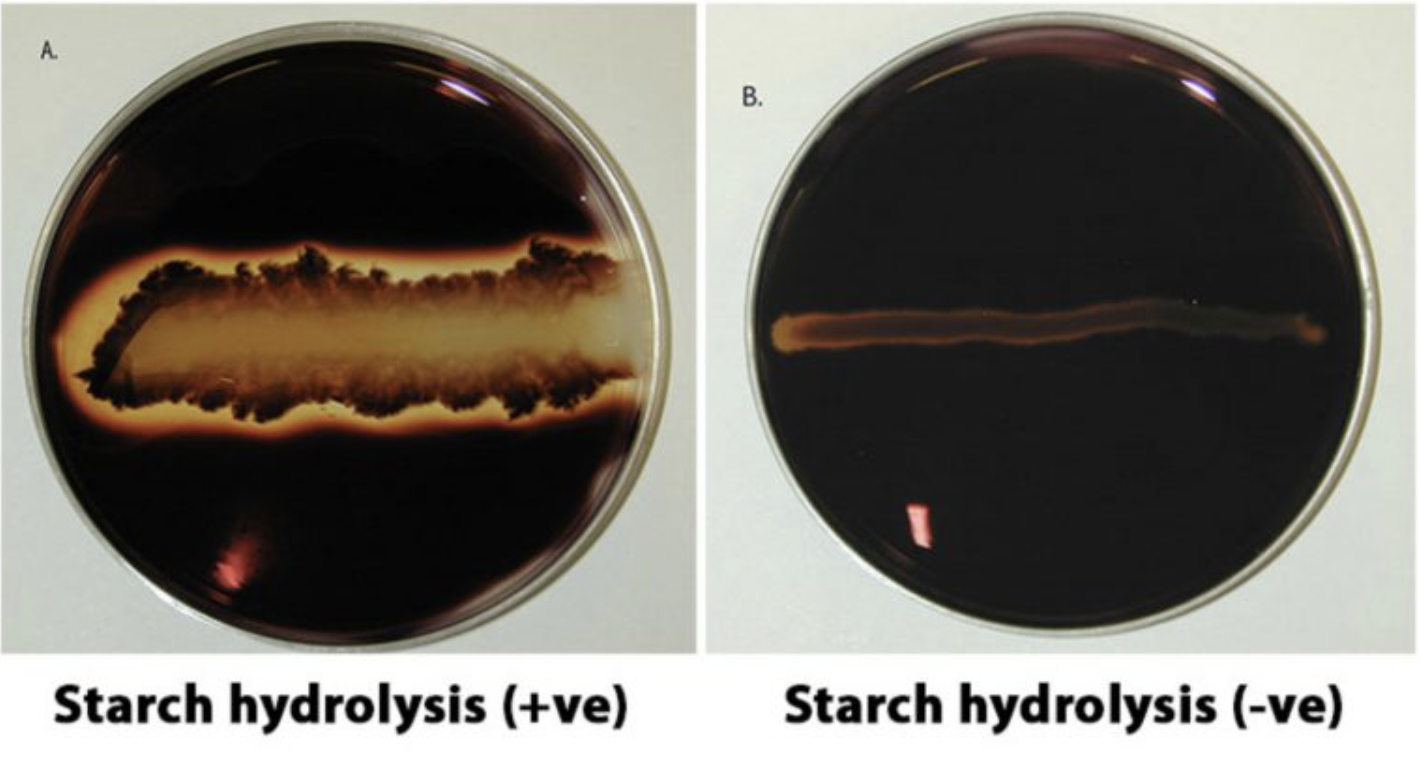
<p>Amylase is present</p>
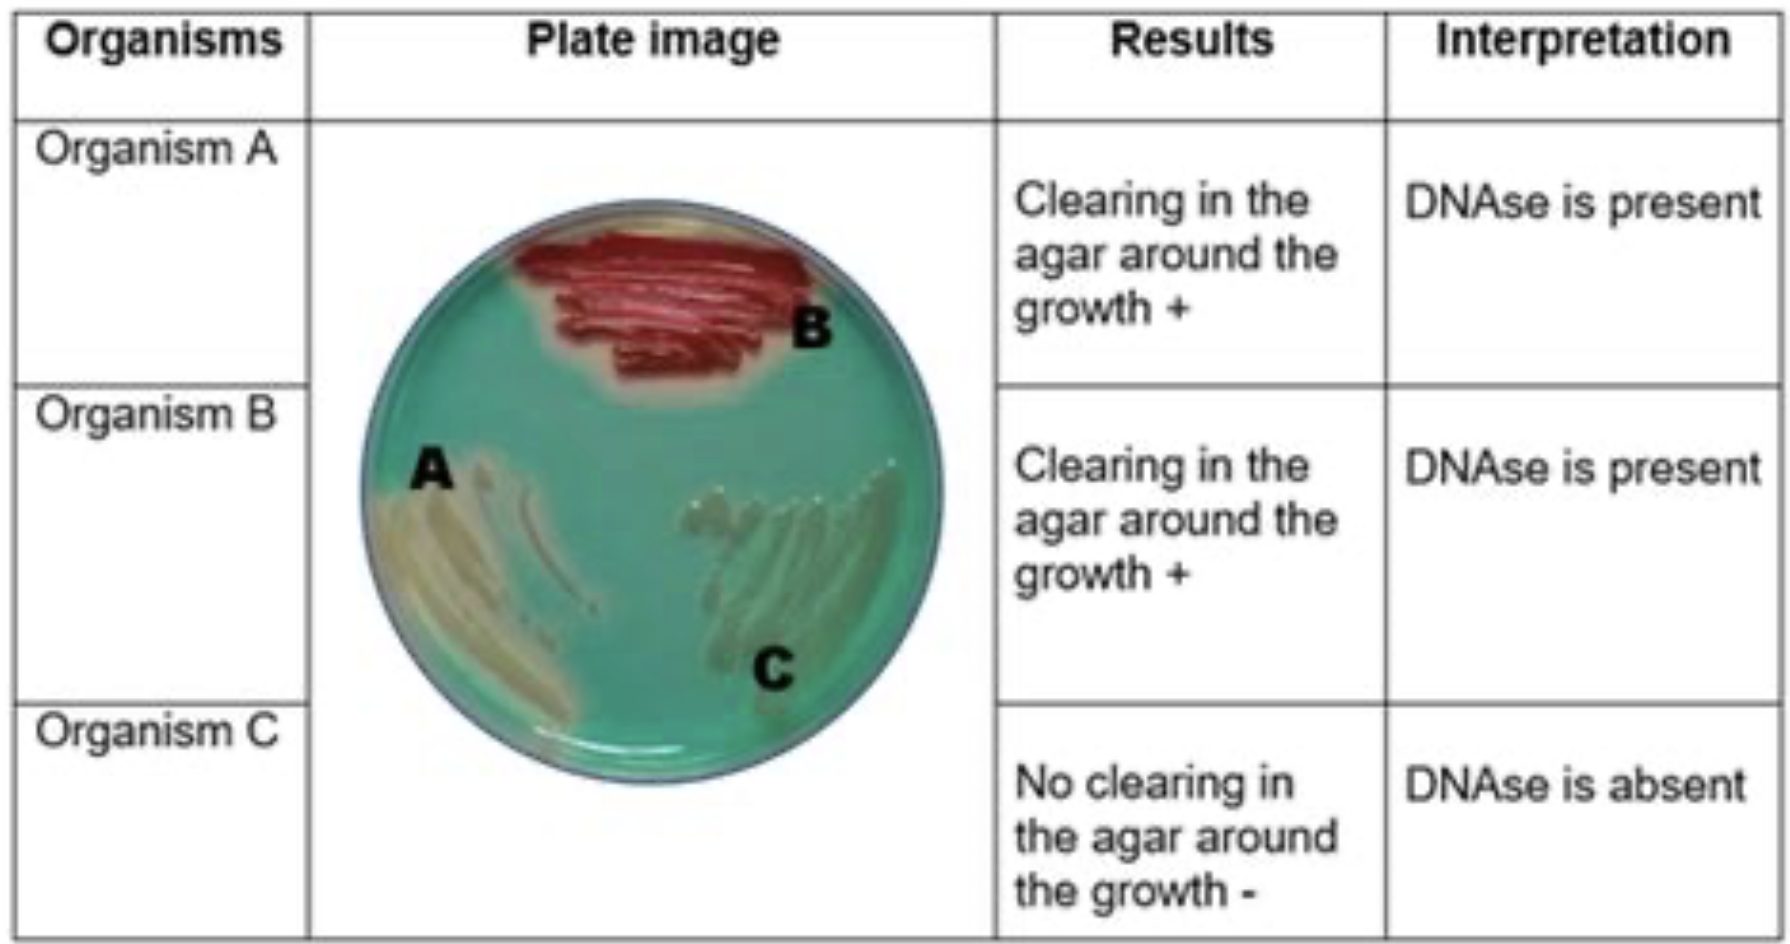
<p>DNase is absent</p>
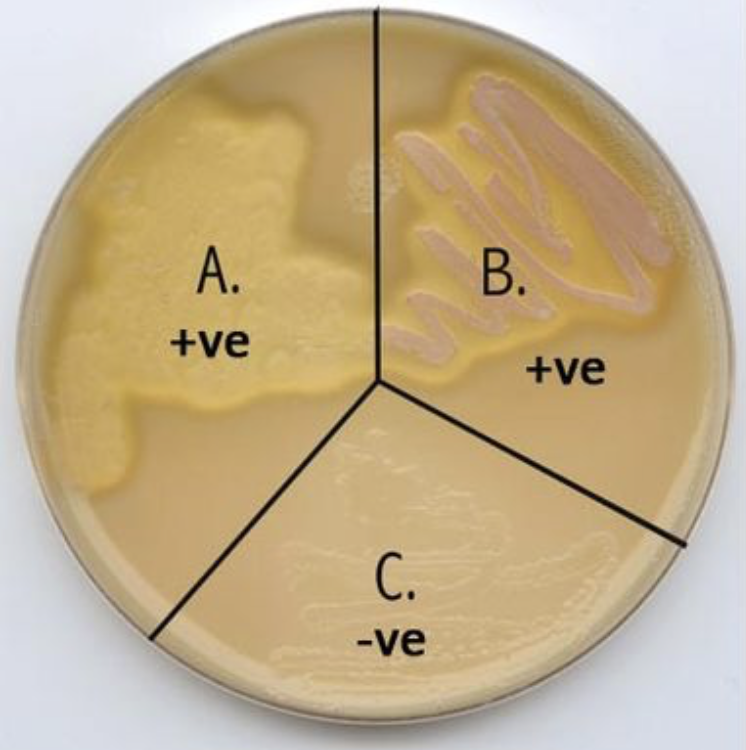
<p>Lipase is absent or not detectable</p>

1/7
Looks like no tags are added yet.
Name | Mastery | Learn | Test | Matching | Spaced | Call with Kai |
|---|
No study sessions yet.
What is a hydrolysis test?
It tests the ability of an organism to produce an exoenxime (an enzyme that is secreted by a cell and functions outside that cell)
Substrates you will test for hydrolysis
Lipid- sugar
Starch- complex sugar
DNA- DNA
Clearing around growth
Amylase is present
No clearing around growth
No amylase is present

Clearing in agar around growth
DNase is present

No clearing in agar around growth
DNase is absent
Clearing in agar
Lipase is present

No clearing in agar
Lipase is absent or not detectable